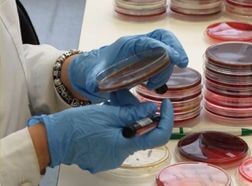

Serviço de Saúde da RAM
Missão
O Serviço de Saúde da RAM, EPERAM, tem como missão:
- Prestar cuidados de saúde, cuidados e tratamentos continuados, cuidados paliativos à população, designadamente aos beneficiários do Serviço Regional de Saúde e aos beneficiários dos subsistemas de saúde, ou de entidades externas que com aquele contratem tais cuidados e a todos os cidadãos em geral, de forma integrada, através de uma rede de serviços de fácil acesso, com uma eficiência técnica e social de elevado nível que permita a obtenção de ganhos em saúde.
Serviço de Saúde da RAM
Siga-nos nas redes sociais